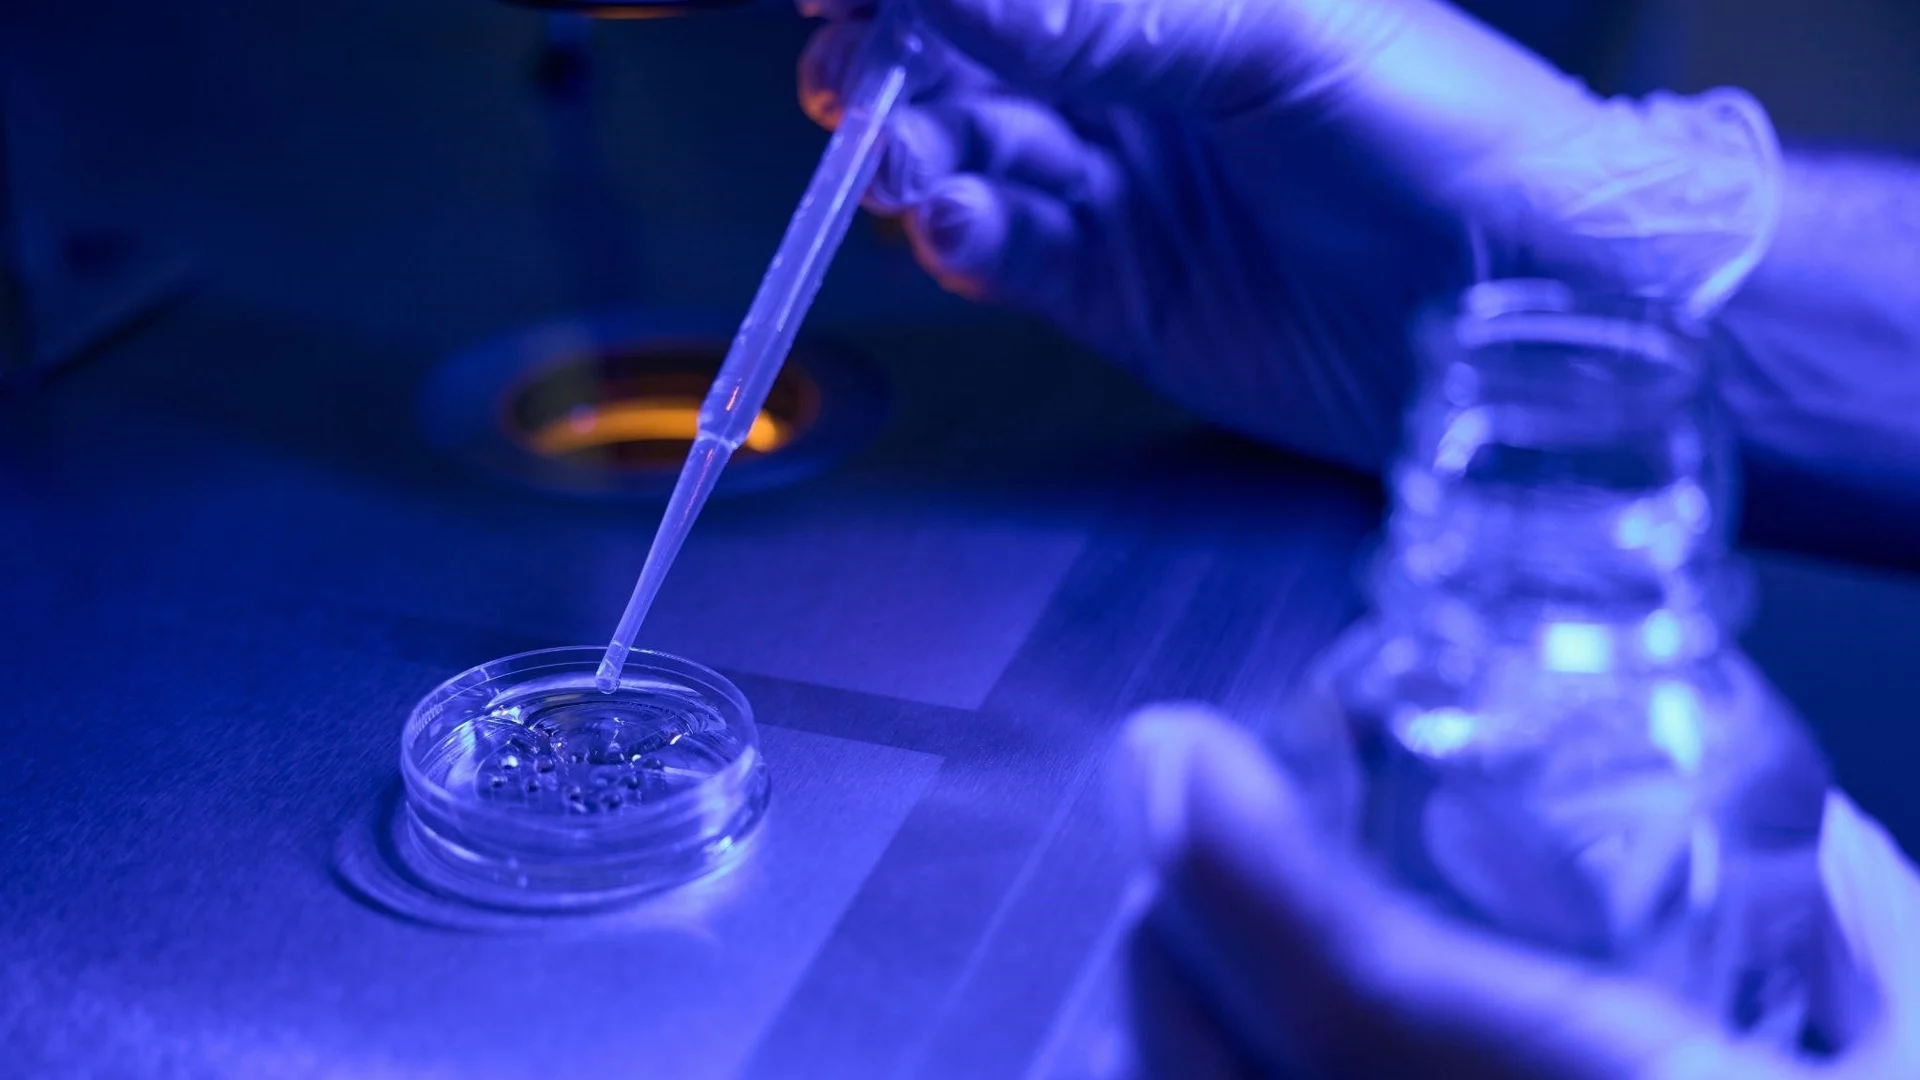
Каква е възрастовата граница при жените за асистираната репродукция?

Новини от Естествен подбор
Ето какво да очакваме от първи епизод на "Ергенът" 3
С пълна палитра от вълнуващи любовни трепети, красиви гледки и силни емоции, тази вечер (21 февруари) най-романтичното риалити в българския ефир – "Ергенът“ – се завръща по bTV, за да покори отново сърцата на зрителите
Прочети повечеПървите отпаднали от Dancing Stars разкриха ИСТИНАТА зад кулисите
“Това да си тръгнеш от първия лайв е ужасно”, каза треньорът на Боряна Баташова, Калоян в предаването “Преди обед”. “Не очаквахме точно това”, добави той, “не е хубаво да се коментират оценките, но 11 точки сумарно си
Прочети повечеМария Бакалова влезе в Dancing Stars
Мария Бакалова се присъедини към гаджето си Валери Григоров в новия сезон на "Денсинг старс". Въпреки слуховете, че са се разделили, те са влюбени и често споделят провокативни селфити от своите пътешествия по света. Бакалова
Прочети повечеКаква е възрастовата граница при жените за асистираната репродукция?
Промените в последните десетилетия предоставиха много възможности на жените в професионален план, което ги постави пред дилема. На деца ли да отдадат младостта си или на кариера? Обикновено децата се изместват за
Прочети повечеЗвезда в 18+ филми влезе в Hell`s Kitchen. Шеф Ангелов няма думи!
27-годишна порнозвезда предизвика фурор пилотния епизод на новия сезон на "Хелс Китчън"! Владимира от Бургас работи като преводач в съда в Барселона и същевременно се занимава със запалената си професия. Докато
Прочети повечеНаталия Кобилкина проговори за шеф Ангелов: Не ме е страх
"Любовта на мъжа не минава през стомаха, минава два пръста под него." Така се шегува психоложката и сексолог Наталия Кобилкина, която влиза в риалити формата "Хелс китчън" по Нова тв. Кобилкина е част от Отбора на златните,
Прочети повечеПървият Ерген и Папи Ханс изумиха в Dancing Stars
Трудно предизвикателство за 16-те участника в реализиращото се шоу "Денсинг Старс". Те трябва да се изправят срещу четири танца - ча-ча, самба, валс и фокстрот. Сред тях е и Виктор Стоянов, първият ерген на България,
Прочети повечеЕто кои ще влязат в къщата на Биг Брадър
Само 15 участници ще застанат пред камерите на новия сезон на „Биг Брадър“, който след дълги години пауза се завръща на екраните. Изборът ще падне върху известни личности, но по-скоро популярни в интернет, а не известни
Прочети повечеУчителка на Ергенът 3 Алек Младенов разкри истината за него: Това беше проблем
Една от най-важните жени в живота на новия ерген Алек Младенов - учителката му от Френската гимназия, госпожа Джемджиева, не спести суперлативите си по адрес на бившия си ученик. "Като ученик той беше идеален, изключителен,
Прочети повечеНе издържа! Ергенът Виктор сподели чувствата си към Мария във ВИДЕО
Със сърце, разбито от болка, ерген №1 се включва в хитовото танцово шоу "Денсинг старс". Само няколко дни преди старта на риалитито на 20 февруари, Виктор Стоянов обяви, че е отново сам, изповядвайки се в социалните
Прочети повечеЗрителите са изумени след първото шоу на "Като две капки вода"
Софи Маринова и Валентина спечелиха благотворителното шоу "Като две капки вода" на Нова, изпълнявайки "Скитница" на Лили Иванова, с Мария Бакалова и Христо Стоичков в журито. Магърдич Халваджиян, рожденикът
Прочети повечеШок в Интернет! Ето какви хора влизат в Hell`s Kitchen
Интересни участници ще бъдат в новия сезон на Hell's Kitchen. Сред 9-те души, които влизат в шоуто на Nova тази година, само двама са опитни в готвенето - Радка Булман и певицата Бони. Останалите са предимно аматьори. Шеф
Прочети повечеВалерия от "Ергенът" показа истинското си лице (СНИМКА)
Валерия Георгиева бе засегната от негативни коментари, като изрази своето недоволство. От момента на появата си в ефира, тя стана обект на много дискусии и спорове сред феновете на „Ергенът”. Мнозинството от зрителите
Прочети повечеНеподозирани предизвикателства в "Един за друг" тази година
Най-позитивното любовно предаване “Един за друг" ще посрещне седем нови двойки във Вилата на любовта. Премиерният епизод на риалити формата ще се излъчи на Свети Валентин, от 20:00 ч. по NOVA. Смелите кандидати да
Прочети повечеТоп 5 хранителни добавки за хубава кожа
Постигането на блестяща, сияйна кожа не означава само намазване с кремове и серуми; започва отвътре. Въпреки че балансираната диета и правилната рутинна грижа за кожата са от съществено значение, понякога телата
Прочети повечеЕрген 1 и Ерген 2 един срещу друг в ТВ предаване!
Тази вечер зрителите на bTV ще имат възможността да видят най-популярните ергени на България в едно предаване! Виктор Стоянов и Евгени Генчев, известни от първите два сезона на "Ергенът", ще се състезават в комедийния
Прочети повечеГатьо от "Игри на волята" влиза в ново риалити. С Кобилкина!
Нова ТВ активно използва личностите, които са се утвърдили в риалити предаванията, като ги включва в нови проекти. Бившият командос Пеньо Гатевски, известен като Гатьо, например, се появи в "Игри на волята" и "Черешката
Прочети повечеДенислава от "Игри на волята" влиза в "Един за друг". Ето с кого!
Денислава от последния сезон на "Игри на волята" изненадва с новината, че ще участва в риалити предаването "Един за друг" на Нова Телевизия. "Ще има нещо вълнуващо. Съжалявам, ако не съм много активна в следващите
Прочети повечеМома от "Ергенът" влиза в Hell`s Kitchen
Феновете на хитовото риалити "Hell’s Kitchen" трябва да се подготвят за ожесточени кулинарни битки тази пролет. Под внимателния поглед на Виктор Ангелов, в Кухнята на Ада отново ще се разрази кулинарна вихрушка със
Прочети повечеРазкриха участници от "Един за друг". Известни са от друг формат!
Риалити звезди присъстват в новия сезон на "Един за друг". Сред тях е Петър, предишен участник в "Фермер търси жена". Той и неговата половинка Галена ще участват в това най-романтично риалити. Ивайло, известен от
Прочети повече

Героите
Анелия Луцинова: Аз съм интроверт, който за кратко доста убедително симулира екстроверт
Най-вероятно сте я гледали на сцена – в някои от най-успешните театрални представления
Прочети повечеЦифром и словом
часа след като си ял чесън не можело да се возиш в автобус – такъв бил законът в Индия преди време.